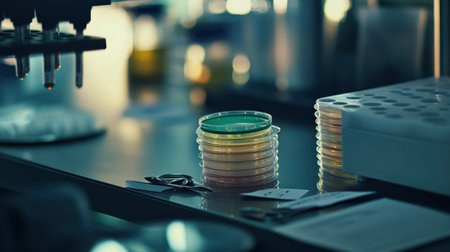
Lab bench with Petri dishes, flasks, and PH indicator chart beside measuring spoonsの素材

素材 - Lab bench with Petri dishes, flasks, and PH indicator chart beside measuring spoons
作品情報
Lab bench with Petri dishes, flasks, and PH indicator chart beside measuring spoons
- ID:255442235
- 作品種別:
- 作者名:sawat burarat
キーワード
- acid
- analyzing
- bacterium
- balance
- biochemistry
- biology
- blood
- car
- chemical
- close-up
- color image
- colors
- comparison
- control
- diabetes
- equipment
- examining
- expertise
- france
- glucose
- hand
- healthcare and medicine
- high angle view
- horizontal
- identity
- illness
- laboratory
- measuring
- medicine
- microbiology
- no people
- one person
- order
- panoramic
- paper
- people
- protein
- reading
- research
- scale
- science
- service
- still life
- studio shot
- uk
- vial
- yeast
類似作品
Close-up transp...
Detail of two p...
Petri dish in a...
glass petri dis...
top view petri ...
petri dishes us...
Glass lab dishe...
microbial cultu...
color liquid in...
Scientific hand...
Scientific hand...
Group of Petri ...
Gloved Hand of ...
Hands, plant sc...
Petri dish with...
Scientific hand...
Pipette with dr...
Medical science...
Biochem test ki...
Development Of ...
Mixed of bacter...
Petri dish
Eco-friendly co...
Medical science...
Petri dishes, t...
Research of vir...
science genetic...
pills and medic...
Pouring liquid ...
Petri dishes (P...
Microbiology la...
Two Petri dishe...
Scientist in gl...
Petri dishes wi...
Viruses and bac...
Medicine. Sperm...
Close-up of bac...
Biochemical Gla...
Petri dishes in...
Pipette with dr...
Top view of pet...
Petri dish with...
Biochem test ki...
laboratory equi...
Test tubes flas...
Two petri dishe...
Lab bench with ...
Close up of lab...
Test-tubes and ...